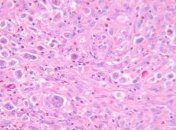
В США ученые нашли новый вид супербактерий, стойких к антибиотикам

Новости по теме Вид
-

Россиянин через посредника в Украине пытался проверную крупную аферу
-

Предлагаем вам насладиться видами известнейших городов с высоты птичьего полета.
-

Издание каталога с описанием всех биотопов Украины - это настоящий прорыв и шаг на встречу защиты природы так, как это делают в европейских странах.
-

Специалисты обнаружили в парке под Харьковом бабочку, занесенную в Красную книгу.
-

Когда вы подходите к зданию, вам становится понятно, почему его называют Белый Храм.
-

Характерный польдерный пейзаж возле дюн Северной Голландии формирует образ этой современной загородной виллы.
-

Матерь природа способна создавать воистину фантастические вещи, и чтобы это доказать не нужно никаких научных данных, достаточно просто посмотреть в зеркало.
-

Архитектура дома сформирована естественным контекстом, который помог определить расположение трех уровней дома, когда они спускаются с холма.
-

Исследователям удалось вырастить стволовые клетки животных.
-

Исследователи впервые наблюдали за подобным процессом в дикой природе.
-

Сейчас популяция этого вида животных насчитывает около 800 особей.
-

В Чехии обнаружили останки неизвестного до этого времени динозавра.
-

Чем старше мы становимся, тем внимательнее нужно подходить к выбору причесок, чтобы самим себе не испортить внешний вид. К сожалению наше…
-

Новый вид шоколада назвали Ruby из-за характерного красного оттенка.
-

Палеонтологи из Аргентины описали самое крупное сухопутное животное, которое жило на планете Земля.
-
В Хьюстоне (США) медики обнаружили новый вид супербактерии.


